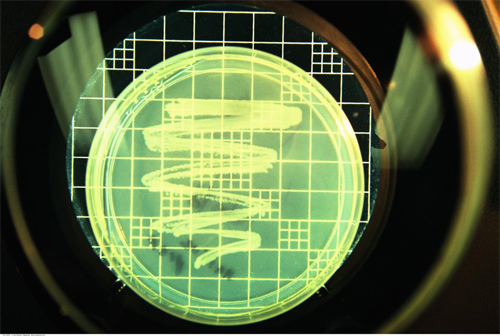
1 副本副本.jpg

多重耐药菌防控攻略:了解、预防、控制,共筑健康防线
随着抗生素的广泛使用,多重耐药菌已经成为全球重大的公共卫生威胁。它所引起的感染复杂、难治,可导致包括泌尿道感染、外科手术部位感染、医院获得性肺炎、导管相关血流感染等常见感染。因此,我们需要提高警惕,加强对多重耐药菌的防控。
一、多重耐药菌常见种类和重点科室
1.常见多重耐药菌:
·耐甲氧西林金黄色葡萄球菌(MRSA)
·耐万古霉素肠球菌(VRE)
·耐碳青霉烯类抗菌药物鲍曼不动杆菌(CR-AB)
·多重/泛耐药铜绿假单胞菌(MDR/PDR-PA)
·耐碳青霉烯类抗菌药物肠杆菌科细菌(CRE)
·产超广谱β-内酰胺酶(ESBLs)细菌等
2.重点防控科室:
·重症监护病房(ICU)
·新生儿室
·血液科病房
·呼吸科病房
·神经科病房
·烧伤病房
·肿瘤科病房
·肾病科病房
·输血科病房等


二、多重耐药菌定植与感染的区别
1.多重耐药菌定植:指在患者送检的临床微生物学样本中分离出多重耐药菌,但没有感染的临床表现。定植可以在呼吸道、皮肤、开放伤口等部位发现。与感染相比,多重耐药菌定植不需要治疗,但同样要执行接触隔离等预防控制措施。
2.多重耐药菌感染:指多重耐药菌定植后发展成感染,表现为临床症状、体征及实验室检查的异常。多重耐药菌感染需要针对性治疗和严格的感染控制措施。

三、多重耐药菌防控措施
1.病原菌监测:定期对多重耐药菌进行监测,以便及时了解耐药菌的分布和变化,为防控策略提供依据。
2.手卫生:严格遵循手卫生规范,包括手卫生时机、手卫生操作等。医务人员需要在适当的时机进行正确的手卫生操作,有效降低耐药菌传播的风险。
3.接触预防:医务人员在进入耐药菌感染或定植患者病房时,需采取接触预防措施,如佩戴手套、隔离衣等,避免交叉感染。
4.环境消毒:对患者周围环境进行定期清洁和消毒,降低耐药菌在环境中的存活和传播风险。
5.抗生素管理:合理使用抗生素,遵循抗生素使用原则,降低耐药菌产生的风险。加强对抗生素的监管,限制滥用抗生素。
6.高危人群防护:针对高危人群,如免疫抑制患者、重症患者等,采取更严格的防护措施,降低感染风险。
7.培训与教育:加强医务人员、患者及家属的多重耐药菌防控知识培训和宣传教育,提高全民的防控意识。
8.预防感染:采取措施预防导管相关血流感染、切口感染、肺炎等与多重耐药菌相关的医院感染。



通过以上多重耐药菌防控措施,我们可以共同努力筑起健康防线,降低多重耐药菌对公共卫生的威胁。
手卫生产品推荐
洁薇柔免洗手消毒凝胶:

专利配方
杀灭分枝杆菌、耐甲氧西林金黄色葡萄球菌(MRSA)、耐万古霉素肠球菌(VRE)、多重耐药鲍曼不动杆菌(MDRAB)
不搓泥,干燥后清爽不黏腻
食用级酒精,添加透明质酸钠,纳米脂质体,护肤均匀全覆盖,提升皮肤屏障
实际无毒、多次皮肤无刺激
开启后有效期可长达120天
洁薇柔速干手消毒液:

改良升级WHO配方
灭活脊灰病毒,杀灭分枝杆菌、耐甲氧西林金黄色葡萄球菌(MRSA)、耐万古霉素肠球菌(VRE)、多重耐药鲍曼不动杆菌(MDRAB)
食用级酒精,添加透明质酸钠
物表清洁消毒产品推荐
爱尔施表面消毒湿巾Ⅱ型:

优质原料,食品可接触
使用无死角,消毒液不收缩
超大张,超强使用量,大尺寸加宽加厚
干燥后无杂质残留
30秒杀灭分枝杆菌、肠道致病菌、化脓性球菌、致病性酵母菌、医院感染常见细菌
30秒物体表面现场消毒实验合格,30秒杀灭耐甲氧西林金黄色葡萄球菌(MRSA)、耐万古霉素肠球菌(VRE)、多重耐药鲍曼不动杆菌(MDRAB)
爱尔施1%过氧化氢消毒湿巾:

优质原料,食品可接触
使用无死角,消毒液不收缩
超大张,超强使用量,大尺寸加宽加厚
干燥后无杂质残留
灭活无包膜亲水病毒,1分钟灭活脊灰病毒、灭活手足口肠道病毒71型
1分钟杀灭耐甲氧西林金黄色葡萄球菌(MRSA)、耐万古霉素肠球菌(VRE)、多重耐药鲍曼不动杆菌(MDRAB)

